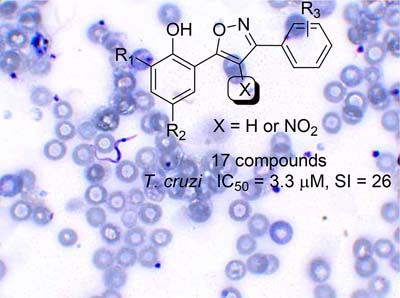

vol. 29, No. 2, 2018, p. 217-434
Antimicrobial resistance is a global concern because is present in every country. Bacterial biofilm is associated with many persistent infections and increased resistance to antibiotics. Diguanylate cyclase enzymes (DGC) are an attractive target for antibiofilm drug intervention. Drug repurposing strategy resulted in DGC inhibitors discovery from therapeutics drugs using the integration of computational and biochemical assays. Details are presented in the Article Identification of Anti-Inflammatory and Anti-Hypertensive Drugs as Inhibitors of Bacterial Diguanylate Cyclases by Helton J. Wiggers, Édson Crusca, Éverton E. D. Silva, Juliana Cheleski, Naiara U. Torres and Marcos V. A. S. Navarro on page 297.
Identification of Anti-Inflammatory and Anti-Hypertensive Drugs as Inhibitors of Bacterial Diguanylate Cyclases
Helton J. Wiggers; Edson Crusca; Éverton E. D. Silva; Juliana Cheleski; Naiara U. Torres; Marcos V. A. S. Navarro
How to cite this article
Antimicrobial resistance is a global concern because is present in every country. Bacterial biofilm is associated with many persistent infections and increased resistance to antibiotics. Diguanylate cyclase enzymes (DGC) are an attractive target for antibiofilm drug intervention. Drug repurposing strategy resulted in DGC inhibitors discovery from therapeutics drugs using the integration of computational and biochemical assays. Details are presented in the Article Identification of Anti-Inflammatory and Anti-Hypertensive Drugs as Inhibitors of Bacterial Diguanylate Cyclases by Helton J. Wiggers, Édson Crusca, Éverton E. D. Silva, Juliana Cheleski, Naiara U. Torres and Marcos V. A. S. Navarro on page 297.
https://dx.doi.org/10.21577/0103-5053.20170141
Articles J. Braz. Chem. Soc. 2018, 29(2), 217-225
Synthesis and Application of Bimetallic Zinc(II) Phenoxy-Imine Complexes as Initiators for Production of Lactide Polymers
Alana L. C. Oliveira; Leonardo C. Ferreira; Marcos L. Dias; Rodrigo S. Bitzer; Marco A. C. Nascimento; Maria de Fátima V. Marques; Laura Crociani
How to cite this article

Bimetallic ZnII complexes with phenoxy-imine ligands were synthesized and used as initiators for lactide polymerization.
https://dx.doi.org/10.21577/0103-5053.20170131
J. Braz. Chem. Soc. 2018, 29(2), 226-231
Nanoporous Gold Surface: An Efficient Platform for Hydrogen Evolution Reaction at Very Low Overpotential
Anandhakumar Sukeri; Mauro Bertotti
How to cite this article

A nanostructured porous gold based electrocatalyst was fabricated via a facile electrochemical approach and an excellent activity with good stability for hydrogen evolution reaction was noticed.
https://dx.doi.org/10.21577/0103-5053.20170132
J. Braz. Chem. Soc. 2018, 29(2), 232-239
A Novel Electrochemical Aptamer Biosensor Based on DNAzyme Decorated Au@Ag Core-Shell Nanoparticles for Hg2+ Determination
Yanling Zhao; Xianmei Xie
How to cite this article

Based on thymine-Hg2+-thymine binding mode (T-Hg2+-T), a sensitive aptamer biosensor was constructed by utilizing functionalized Au@Ag core-shell nanoparticles as labels for detection of Hg2+.
https://dx.doi.org/10.21577/0103-5053.20170133
J. Braz. Chem. Soc. 2018, 29(2), 240-247
Binary Blends of Biodiesel from Macauba (Acromia aculeata) Kernel Oil with Other Biodiesels
Willian L. G. da Silva; Acacia A. Salomao; Patricia T. de Souza; Marina Ansolin; Matthieu Tubino
How to cite this article

The oil from the kernel of macauba presents high stability to oxidation, property that is transferred to its biodiesel, which also presents low cold filter plugging point. Such properties are inherited by its blends with biodiesels obtained from other vegetable oils.
https://dx.doi.org/10.21577/0103-5053.20170134
J. Braz. Chem. Soc. 2018, 29(2), 248-257
Evaluation of Crocins in Cheeses Made with Saffron by UHPLC
Mena Ritota; Maria Mattera; Maria Gabriella Di Costanzo; Pamela Manzi
How to cite this article

Cheeses made with saffron are expected to provide an added value for consumers, due to saffron bioactive compounds. This UHPLC method seems to be useful to detect saffron crocins in dairy products.
https://dx.doi.org/10.21577/0103-5053.20170135
J. Braz. Chem. Soc. 2018, 29(2), 258-268
Hirshfeld Surfaces and Nonlinear Optics on Two Conformers of a Heterocyclic Chalcone
Jean M. F. Custodio; Caua A. Moreira; Clodoaldo Valverde; Gilberto L. B. de Aquino; Basílio Baseia; Hamilton B. Napolitano
How to cite this article

The nature of crystal packing of an heterocyclic chalcone, investigated by Hirshfeld surfaces, and its potential nonlinear optical properties.
https://dx.doi.org/10.21577/0103-5053.20170136
J. Braz. Chem. Soc. 2018, 29(2), 269-277
Synthesis of 3,5-Diarylisoxazole Derivatives and Evaluation of in vitro Trypanocidal Activity
Aline A. N. de Souza; Viviane F. Xavier; Gleicekelly S. Coelho; Policarpo A. Sales Junior; Alvaro J. Romanha; Silvane M. F. Murta; Claudia M. Carneiro; Jason G. Taylor
How to cite this article
A series of novel substituted isoxazoles were prepared and tested for in vitro anti T. cruzi activity. The lead compound is equally as potent as reference drug benzonidazole.
https://dx.doi.org/10.21577/0103-5053.20170137
J. Braz. Chem. Soc. 2018, 29(2), 278-284
Use of Amphiphilic Composites based on Clay/Carbon Nanofibers as Fillers in UHMWPE
Claudilene R. Silva; Rochel M. Lago; Helena S. Veloso; Patrícia S. O. Patricio
How to cite this article

The more efficient interaction of the fillers based on hydrophobic surface nanostructures with the hydrophobic UHMWPE chains leading to a much higher dispersion of the filler particles throughout the polymeric matrix.
https://dx.doi.org/10.21577/0103-5053.20170138
J. Braz. Chem. Soc. 2018, 29(2), 285-296
Evaluation of the Concentration of Cu, Zn, Pb and Cr in Different Fish Species from the Sao Gonçalo Channel in Pelotas-RS, Brazil
Marcelo M. Alves; Aline L. Medina; Ane Martiele T. Pinto; Ana Clara N. Antunes; Pedro José Sanches Filho; Anderson S. Ribeiro; Mariana A. Vieira
How to cite this article

The concentration of Cu, Zn, Cr and Pb in different species of fish collected in the estuarine and limnic regions of the Sao Gonçalo channel in Pelotas City were determined.
https://dx.doi.org/10.21577/0103-5053.20170139
J. Braz. Chem. Soc. 2018, 29(2), 297-309
Identification of Anti-Inflammatory and Anti-Hypertensive Drugs as Inhibitors of Bacterial Diguanylate Cyclases
Helton J. Wiggers; Edson Crusca; Éverton E. D. Silva; Juliana Cheleski; Naiara U. Torres; Marcos V. A. S. Navarro
How to cite this article

Virtual screening applied to FDA-approved drugs allowed the inhibitor discovery for enzymes diguanylate ciclases involved in the bacterial biofilm formation.
https://dx.doi.org/10.21577/0103-5053.20170141
J. Braz. Chem. Soc. 2018, 29(2), 310-319
Surface Imprinting of Silica Gel by Methyldopa and Its Application in the Solid Phase Extraction Procedure
Mohammad Taghi Vardini; Leila Mardani
How to cite this article

Surface of the activated silica gel was grafted with the complex of MTD-APS. The custom made holes to the MTD remain on the surface of molecularly imprinted adsorbent.
https://dx.doi.org/10.21577/0103-5053.20170142
J. Braz. Chem. Soc. 2018, 29(2), 320-327
Functionalization of Bentonite and Vermiculite after the Creation of Structural Defects through an Acid Leaching Process
Dorsan S. Moraes; Lucas C. R. Miranda; Rômulo S. Angélica; Geraldo N. Rocha Filho; José R. Zamian
How to cite this article

Schematic model of a 2:1 layer structure of the organofunctionalized materials present in this work, suggesting the superficial acid sites created.
https://dx.doi.org/10.21577/0103-5053.20170143
J. Braz. Chem. Soc. 2018, 29(2), 328-333
SBA-15 as a Support for Nickel-Based Catalysts for Polymerization Reactions
Anderson J. Schwanke; Cristiano Favero; Rosana Balzer; Katia Bernardo-Gusmao; Sibele B. C. Pergher
How to cite this article

Polymerization reaction with a nickel-based catalyst supported on SBA-15 mesoporous materials.
https://dx.doi.org/10.21577/0103-5053.20170144
J. Braz. Chem. Soc. 2018, 29(2), 334-342
Preparation of Tetraethylenepentamine Modified Magnetic Graphene Oxide for Adsorption of Dyes from Aqueous Solution
Xiaosheng Tang; Ping Tang; Liangliang Liu
How to cite this article

Tetraethylenepentamine modified magnetic graphene oxide nanomaterial was prepared and it had a good adsorption ability to remove dyes in wastewater.
https://dx.doi.org/10.21577/0103-5053.20170145
J. Braz. Chem. Soc. 2018, 29(2), 343-352
Synthesis, Antioxidant Activity, Acetylcholinesterase Inhibition and Quantum Studies of Thiosemicarbazones
Larissa Sens; Aldo S. de Oliveira; Alessandra Mascarello; Inês M. C. Brighente; Rosendo A. Yunes; Ricardo J. Nunes
How to cite this article

The current study investigated the antioxidant activity, acetylcholinesterase inhibition and quantum studies of thiosemicarbazones.
https://dx.doi.org/10.21577/0103-5053.20170146
J. Braz. Chem. Soc. 2018, 29(2), 353-362
Alkaline Solubilization of Chicken Tissues Monitored by Raman Spectroscopy Followed by Pb Determination by GF AAS
Náira S. Campos; Marcone A. L. de Oliveira; Celly M. S. Izumi; Rafael A. de Sousa
How to cite this article

Lead content was evaluated in chicken viscera by GF AAS after solubilization with tetramethylammonium hydroxide (TMAH). Sample preparation was monitored by Raman spectroscopy and SEM-EDS.
https://dx.doi.org/10.21577/0103-5053.20170148
J. Braz. Chem. Soc. 2018, 29(2), 363-370
Morpho/Proteomic Comparative between High Grade Pleomorphic Sarcoma and Metastasis Diagnosed in an Old Captive Common Hippo
Adriana R. Silva; José T. J. G de Lacerda; Bernadete Faria; Isabela W. da Cunha; Vitor P. de Andrade; Nilson A. Assunçao
How to cite this article

Mass spectrometry analysis as additional tool for description and differentiation of tumor physiopathology: a comparative proteomic study between pheomorphic sarcoma, metastasis and healthy tissues.
https://dx.doi.org/10.21577/0103-5053.20170149
J. Braz. Chem. Soc. 2018, 29(2), 371-379
Effect of Selenite and Selenate Application on Mineral Composition of Lettuce Plants Cultivated Under Hydroponic Conditions: Nutritional Balance Overview Using a Multifaceted Study
Emanueli do Nascimento da Silva; Mirla Cidade; Gabriel Heerdt; Rafael L. Ribessi; Nelson H. Morgon; Solange Cadore
How to cite this article

Selenate and selenite enrichment in the Veneza Roxa lettuce was carried out and the mineral composition was evaluated using ICP OES, PCA and molecular modeling. Selenate-biofortified lettuce showed a synergetic effect with S and Mo while selenite-biofortified lettuce showed a synergetic effect with Mn, P, Mg and Ca.
https://dx.doi.org/10.21577/0103-5053.20170150
J. Braz. Chem. Soc. 2018, 29(2), 380-389
Suspended and Immobilized TiO2 Photocatalytic Degradation of Estrogens: Potential for Application in Wastewater Treatment Processes
Marcus V. de Liz; Rubia M. de Lima; Bianca do Amaral; Belisa A. Marinho; Jessica T. Schneider; Noemi Nagata; Patricio Peralta-Zamora
How to cite this article

Photocatalytic degradation of estrogens by suspended and immobilized TiO2 were compared in aqueous and wastewater samples. The EE2 degradation products were monitored by GC-MS/MS.
https://dx.doi.org/10.21577/0103-5053.20170151
J. Braz. Chem. Soc. 2018, 29(2), 390-397
Comparative Study of the Lipid Profiles of Oils from Kernels of Peanut, Babassu, Coconut, Castor and Grape by GC-FID and Raman Spectroscopy
William S. Martini; Brenda L. S. Porto; Marcone A. L. de Oliveira; Antonio C. Sant'Ana
How to cite this article

A fast evaluation of the degree of unsaturation and the presence of oxidized products in oil samples by Raman spectroscopy, through the identification of marker bands, assigned by supporting of GC-FID analyses of standard fatty acids.
https://dx.doi.org/10.21577/0103-5053.20170152
J. Braz. Chem. Soc. 2018, 29(2), 398-403
Absolute Configuration of Solenopsis Piperidines is a Tool to Classify Fire Ants (Formicidae:Myrmicinae)
Francisca D. S. Araújo; Marcela A. Botelho; José R. Trigo; Anita J. Marsaioli
How to cite this article

Chiral GC chromatogram of the peak discrimination of 2-methyl-6-undecylpiperidine trifluoroacetamide stereoisomers (synthetic standard mixture).
https://dx.doi.org/10.21577/0103-5053.20170153
J. Braz. Chem. Soc. 2018, 29(2), 404-411
Thermal Properties and Kinetics of Al/α-MnO2 Nanostructure Thermite
Jia-Xing Song; Xiang Fang; Tao Guo; Feng-Li Bei; Wen Ding; Xiao-Nan Zhang; Miao Yao; Hong-Jun Yu
How to cite this article

Thermal properties and kinetics of Al/α-MnO2 nanostructure thermite was reported in this work. According to DSC curves, the heat release and onset temperature were measured. Then the changes of activation energy on extent of conversion (α) for kinetics of Al/α-MnO2 thermite were obtained by using isoconversional method.
https://dx.doi.org/10.21577/0103-5053.20170154
J. Braz. Chem. Soc. 2018, 29(2), 412-418
Catalytic Behaviors of CoII and MnII Compounds Bearing α-Diimine Ligands for Oxidative Polymerization or Drying Oils
Gilvan E. S. Lima; Everton V. Nunes; Roberta C. Dantas; Carlos A. de Simone; Mario R. Meneghetti; Simoni M. P. Meneghetti
How to cite this article

Metal carboxylate complex modified with nitrogen ligands used as catalyst to oxidative polymerization of drying oils.
https://dx.doi.org/10.21577/0103-5053.20170155
J. Braz. Chem. Soc. 2018, 29(2), 419-429
Enantiomeric Ratio Changes of Terpenes in Essential Oils from Hybrid Eucalyptus grandis x E. tereticornis and its Pure Species
Cecilia Naspi; Agustín A. Costa; Alejandro Lucia; Paola G. Audino; Hector M. Masuh
How to cite this article

Fractionation of essential oils from Eucalyptus grandis x E. tereticornis, and its parental taxa, by HPLC followed by GC-MS analysis using two columns in series, allowed to determinate the enantiomeric excesses of selected monoterpenes. Significant differences were found in the enantiomeric ratios in monoterpene alcohols between the three essential oils.
https://dx.doi.org/10.21577/0103-5053.20170156
Short Report J. Braz. Chem. Soc. 2018, 29(2), 430-434
Fast Screening of Solvents for Simultaneous Extraction of Furfural, 5-Hydroxymethylfurfural and Levulinic Acid from Aqueous Solution Using SMD Solvation Free Energies
Ellen V. Dalessandro; Josefredo R. Pliego Jr.
How to cite this article

Automated computational screening of 178 solvents for extraction of organic chemicals from aqueous phase.
https://dx.doi.org/10.21577/0103-5053.20170140
Online version ISSN 1678-4790 Printed version ISSN 0103-5053
Journal of the Brazilian Chemical Society
JBCS Editorial and Publishing Office
University of Campinas - UNICAMP
13083-970 Campinas-SP, Brazil
Free access










